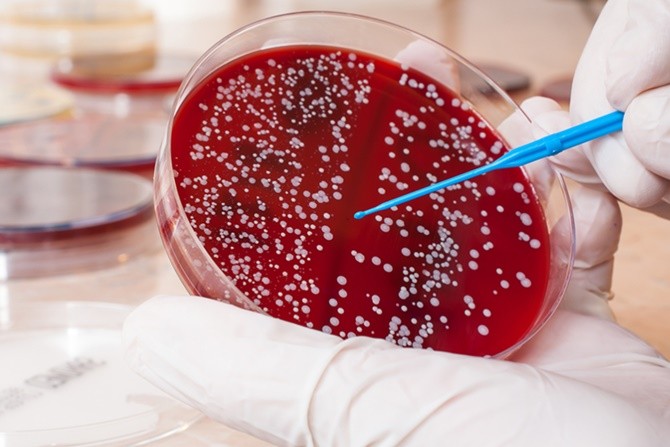

Ilustrasi kanker darah.
JawaPos.com - Kepergian mantan Ibu Negara Kristiani Herrawati alias Ani Yudhoyono memang meninggalkan luka yang dalam bagi keluarga dan seluruh rakyat Indonesia. Ani Yudhoyono meninggal dunia di Singapura setelah berjuang melawan kanker darah.
Namun, terlepas dari kasus penyakit yang diderita istri Presiden ke-6 Susilo Bambang Yudhoyono, kanker darah sendiri memiliki berbagai jenis. Secara umum, kanker darah memang memengaruhi produksi dan fungsi sel darah.
Sayangnya, banyak orang yang menganggap kanker darah adalah leukemia. Padahal leukemia adalah hanya salah satu jenis kanker darah.
Pakar Kesehatan dari Fakultas Ilmu Keperawatan Universitas Indonesia (FIK UI), Agung, menjelaskan memang kanker darah memiliki prognosis (kemungkinan penyembuhan penyakit) yang tidak begitu baik pada beberapa pasien. Hal itu bisa disebabkan berbagai faktor.
Faktor usia pun menjadi salah satu penyebab kondisi penurunan kondisi pasien dengan sangat cepat. Semakin lanjut usia pasien, angka persentase kematiannya akan kanker darah bisa semakin tinggi.
"Misalnya leukemia akut lebih cepat mengakibatkan penurunan kondisi tubuh pasien dibandingkan yang kronik, semakin lanjut usia angka persentase kematian pasien leukemia akan semakin tinggi," katanya kepada JawaPos.com, Sabtu (1/6).
Sedangkan, dilansir dari Hematology.org, Minggu (2/6), sebagian besar kanker ini bermula di sumsum tulang tempat darah diproduksi. Sel punca di sumsum tulang matang dan berkembang menjadi tiga jenis sel darah: sel darah merah, sel darah putih, atau trombosit. Pada sebagian besar kanker darah, proses pengembangan sel darah normal terganggu oleh pertumbuhan yang tidak terkontrol dari jenis sel abnormal.
Sel-sel darah yang abnormal ini mencegah darah melakukan banyak fungsinya, seperti melawan infeksi atau mencegah pendarahan yang serius. Pertumbuhan sel-sel abnormal ini begitu tak terkendali lagi.
Photo
Annisa Pohan bersama Susilo Bambang Yudhoyono mendampingi Ani Yudhoyono yang dirawat di National University Hospital (NUH) pada 4 April. Ani Yudhoyono meninggal setelah melawan kanker darah. (Instagram @aniyudhoyono)
Berikut penjelasan tiga jenis utama kanker darah, termasuk Leukimia.
Leukemia
Leukemia adalah sejenis kanker yang ditemukan dalam darah dan sumsum tulang, disebabkan oleh produksi sel-sel darah putih abnormal yang cepat. Tingginya jumlah sel darah putih yang abnormal tidak mampu melawan infeksi, dan mereka merusak kemampuan sumsum tulang untuk menghasilkan sel darah merah dan trombosit.
Limfoma
Limfoma adalah jenis kanker darah yang memengaruhi sistem limfatik, yang menghilangkan cairan berlebih dari tubuh dan menghasilkan sel-sel kekebalan. Limfosit adalah jenis sel darah putih yang melawan infeksi. Limfosit abnormal menjadi sel limfoma, yang berkembang biak dan berkumpul di kelenjar getah bening dan jaringan lainnya. Seiring waktu, sel-sel kanker ini merusak sistem kekebalan tubuh.
Myeloma
Myeloma adalah kanker sel plasma. Sel plasma adalah sel darah putih yang menghasilkan antibodi penangkal penyakit dan infeksi dalam tubuh Anda. Sel-sel myeloma mencegah produksi antibodi yang normal, membuat sistem kekebalan tubuh melemah dan rentan terhadap infeksi.

50 Unit Mobil Koperasi Desa Merah Putih Tiba di Wonogiri, Dandim 0728/Wonogiri: Saran Saya Tidak Usah Digunakan Dulu Mobilnya
7 Tahun Tak Terkalahkan! Bernardo Tavares Wajib Jaga Harga Diri Persebaya Surabaya di Derbi Jawa Timur Lawan Arema FC
15 Rekomendasi Restoran Terbaik Dekat Tugu Muda Semarang: Surganya Kuliner yang Wajib Dicoba Pelancong dan Wisatawan!
14 Rekomendasi Kuliner Depok untuk Keluarga, Tempat Makan Nyaman dengan Menu Beragam
Jadwal Lengkap MotoGP Spanyol 2026! Misi Berat Veda Ega Pratama dan Mario Aji dari Barisan Belakang di Jerez
Pesan Haru dari Ernando Ari! Dukungan Diam-Diam Bikin Milos Raickovic Bangkit di Persebaya Surabaya
Terdepak dari Puncak Klasemen Liga Inggris, Bayang-bayang Kegagalan Juara di Akhir Musim kembali Menghantui Arsenal
18 Rekomendasi Sarapan Pagi di Bandung Paling Sedap, Sederet Kuliner Mantap yang Wajid Disantap
Profil Agnes Aditya Rahajeng, Pemenang Puteri Indonesia 2026
Kabar Gembira! Gubernur Banten Resmi Hapus Pajak Kendaraan Bermotor, Ini Syaratnya!
